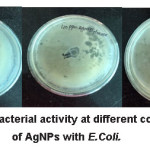
Figure 6

Designing Fructose Stabilized Silver Nanoparticles for Mercury(II) Detection and Potential Antibacterial Agents
1Department of Chemistry, C.B.S.H., G. B. Pant University of Agriculture and Technology, Pantnagar, Uttarakhand, India.
2 Department of Chemistry, D.I.T University, Mussoorie Diversion Road, Makkawala, Dehradun, Uttarakhand, India.
Corresponding Author E-Mail: smiitr@gmail.com
DOI : http://dx.doi.org/10.13005/msri/150305
ABSTRACT:The synthesis of fructose stabilize silver nanoparticles (AgNPs) was attempted in the proposed work. It was found that developed AgNPs played an important role as colorimetric nanoprobes for the estimation of metal ions. The prepared AgNPs were characterized by UV-Vis, IR, XRD, SEM techniques. XRD-pattern of AgNPs, concluded that particles are well dispersed and present in a fcc system and average size was found to be 16.6 nm. AgNPs displayed specific and sensitive recognition to Hg2+ by colorimetric analysis, as in the presence of Hg2+ ions yellow color of AgNPs solution changes to colorless. Synthesized AgNPs also play vital role in antimicrobials. Microbiological test shows that AgNPs are highly active against E.Coli and provide a safer alternative to conventional antibacterial agents. The optical florescence’s microscopy images of AgNPs shows good florescent results, which showed AgNPs with fructose capping agents, might be used as fluorescent sensing materials to sense biological materials.
KEYWORDS:Antimicrobials Agents; Hg(II) Sensing; SEM; Silver Nanoparticles; XRD
Introduction
Mercury is a very toxic element and its contamination can induce a number of severe adverse effects on human health viz. kidney toxicity, neurological damage, paralysis, chromosome breakage and birth defects.1,2 Mercury pollution is mainly occurs through stable water-soluble divalent mercuric ions. Due to serious problems of mercury pollution, efforts are being made to develop new mercury-sensing strategies that can detect mercury ions in the environment3,4 Advancement in the field of colorimetric sensors has fascinated selective and sensitive identification of metal ions in environmental samples.5 Colorimetric assay of metal ions with nanoparticles showed, that the molecular recognition can be transformed into color change, which can be easily observed by the naked eye.6-12 Depending on their size, shape, degree of aggregation and sensitive surface, novel metallic nanoparticles can appears in different colours and emanate bright resonance light scattering of various wavelengths. Therefore, spherical nanoparticles with unique shape dependent properties can be extensively explored as colorimetric probes with the help of recognition moiety for sensing a wide range of analytes and targets, such as metallic cations, nucleic acids, proteins, cells, etc.13-21 Colorimetric sensing detection of Hg2+ ions is done by Silver nano particles (AgNPs), in which AgNPs are more selective as compared to other transition metal ions. In the presence of Hg2+, the yellow AgNPs solution was turned to colorless, accompanying the broadening and blue shifting of SPR band.22,23 According to this mechanism, it can be expected that after addition of Hg2+ ions to AgNPs, Hg2+ ion bounds to the AgNPs surface to move stabilizer compounds (fructose) away from the silver surface, and as a result, a redox reaction would be occurred between silver and Hg2+ ions.
 Click on image to enlarge Click on image to enlarge |
Silver is also known to be a disinfectant for several centuries and has been widely used in the treatment of clinical diseases, including newborn eye prophylaxis and topical burn wounds.24,25 AgNPs also show bactericidal effects and hence a high surface to volume ratio is also important.26 AgNPs can be prepared chemically as well as by biological methods in which green synthesized AgNPs are prepared using plants like Hadysarum, soap root plant etc. In this study, common monosaccharides fructose as reductant, are used to stabilize AgNPs, as it provide low cost and well disperse nanoparticles.27,28 AgNPs in low concentration in aqueous and organic solutions are much easier to prepare, their scaling-up requires a careful control of experimental conditions in order to avoid disparity from batch to batch. Normally, dilute solution of metal salt, surfactant and reducing reagent leads to the formation of clear golden yellow colloidal solution.29 An increase in molar concentration of the reagents generally results in an increase in particle size and agglomeration among the particles.30 AgNPs giving a golden yellow color in aqueous solution due to the excitation of surface plasmon resonance vibrations (SPR band) in AgNPs.22
It is well known that silver ions and silver-based compounds are highly toxic to microorganisms31,32 showing strong bacterial effects on as many bacteria including E. Coli.33,34 The antimicrobial studies of AgNPs against E.Coli was investigated by different scientists as a model for Gram-negative bacteria.35 Fluorescence spectroscopy studies indicate that bacterial growth stopped immediately after addition of E.Coli to the AgNPs solution, with release immediately of cellular green fluorescent protein into the medium. Fluorescence confocal laser scanning and scanning electron microscopy showed attachment of the bacteria to the composite and their subsequent fragmentation.36
Experimental
Chemicals and Materials
Fructose, Silver Nitrate, Ammonium Hydroxide, Mercuric Chloride, Chromium Chloride, Manganese Chloride, Ferric Chloride, Cobalt Nitrate, Nickel Chloride, Copper Chloride, Zinc Chloride, Cadmium Chloride, Sodium Chloride, Magnesium Chloride, Lead Nitrate, Nutrient Agar, Hydrochloric Acid, Ethanol and other solvents were purchased from S.D. Fine Chemicals India. E.Coli were purchased from Central Drug House Private Limited.
Instrumentation
IR spectra were obtained with KBr pellets on a Nicolet Shimadzu FTIR spectrometer in the range of 4,000–400 cm-1. UV-Vis. absorption spectra were recorded on a Shimadzu 200-800 nm diode array spectrophotometer. SEM analysis of synthesized AgNPs was carried out by using field emission scanning electron microscope (Carl Zeiss NTS GmbH, Oberkochen (Germany)) equipped with EDX analysis facility. For SEM analysis, 1 mg of sample was dispersed in 5 ml ethanol and 30 µl of dispersed sample was placed onto brass stubs. Powder X-ray diffraction measurements of the synthesized Ag nano particles were performed using powder X-ray diffractometer (model-ISO-DEBYEFLEX-2002-RICH, SEIFERT & CO) using CuKα radiation.
Preparation of Silver Nanoparticles
The synthesis of AgNPs follows a green synthetic procedure as described in literature for some other small biomolecules.37 Synthesis of spherical silver nanoparticles by simple and low cost chemical route was carried out. Well-dispersed silver nanoparticles were prepared by reducing silver nitrate (AgNO3) with fructose could provide a safer alternative to conventional. For the preparation of fructose capped silver nanoparticles 100 ml aqueous solution of 0.001 M AgNO3 solution, concentrated NH4OH was mixed slowly to make a clear solution of Ag[NH3]2+ complex. After that excess ammonium hydroxide solution was added to maintain pH~12. Then 100 ml 0.025 M aqueous solution of fructose solution was added to the basic silver nitrate solution. This reaction mixture was heated upto 50-550C temperature until yellow colloidal solution of AgNPs was obtained. After 4-5 hrs. yellow colloidal solution of AgNPs were observed, as in scheme 1.
 Click on image to enlarge Click on image to enlarge |
Result and Discussion
Characterization of fructose capped AgNPs with UV and IR- spectroscopy
Then UV spectroscopic absorption peak of silver nanoparticles was observed at 278 nm. After one week it was shifted to 270 nm, two weeks at 268 nm and after three weeks it was observed at 262 nm and 248 nm. It can be say that with the increase in time it shifts to the lower wavelength.
IR measurements were carried out to identify the possible molecules responsible for reduction of Ag+ ions and capping of reduced AgNPs. The peaks observed at 3433 cm-1, 2926 cm-1, 1649 cm-1, 1383 cm-1 by -OH, -C-H, -C=O, and –NO2 groups respectively.
Powder X-Ray Diffraction pattern of synthesized AgNPs
The XRD patterns of synthesized AgNPs using fructose were considered. All observed peaks with respect to 2θ values known for silver representing the 111, 200, 220, 311 and 222 (Fig. 1) crystal planes due to Bragg’s reflections are present. A mathematical method of the Bragg’s peaks was undertaken to calculate the crystallite size using the Scherrer formula, D= kλ/βcosθ where D is the crystallite size, k is a constant (= 0.9 assuming that the particles are spherical), λ is the wavelength of the X-ray radiation, β is the line width and θ is the angle of diffraction. The average particle size of synthesized AgNPs obtained from scherrer’s formula in XRD data is found to be about 16.6 nm. (Table 1). D spacing value (in nm) of synthesized Ag nano particles is given here in the Table 2.
Figure 1: Powder XRD pattern of synthesized AgNPs
 Click on image to enlarge |
Crystallite size of the AgNPs from the XRD data
The crystallite size (D) of synthesized Ag nano particles at 111 planes has been determined using Scherer’s formula

Β = Full width half maxima (in Radians)
Wave length (λ) for Cu source = 1.54Å
The broadening due to instrument was removed by introduction of the width of silica as standard.
Table 1: d spacing value of synthesized Ag nano particles.
|
Plane |
2θ (in degree) |
θ (in degree) |
dhkl in Å n=1 and λ for Cu source=1.54Å |
|
111 |
38.26 |
19.13 |
2.35 |
|
200 |
44.24 |
22.12 |
2.04 |
|
220 |
64.32 |
32.16 |
1.45 |
|
311 |
77.22 |
38.61 |
1.23 |
|
222 |
81.26 |
40.63 |
1.18 |
Table 2: Characterization parameters for AgNPs as per XRD data
|
Plane |
2q (in degree) |
β (FWHM, in degree) after subtracting broadening due to instrument |
β= FWHM (rad)
|
(in nm) |
|
(111) |
38.26 |
0.5045 |
88 |
16.6 |
From powder XRD-pattern of fructose capped AgNPs, it has been concluded that particles are present in a face centered cubic system.
Scanning Electron Microscopic and Optical fluorescence microscopic images of synthesized AgNPs
(Fig. 2a) represents SEM image of AgNPs using fructose. It reveals that AgNPs were spherical and particles form cluster due to agglomeration. The optical flourescence′s microscopy images (Fig. 2b) of AgNPs shows good florescent results that indicate that AgNPs with fructose capping agents might be used as fluorescent sensing materials to sense biological materials in future.
Figure 2: SEM image (a) and Optical fluorescence’s microscopy images (b) of AgNPs using
 Click on image to enlarge |
Colorimetric Detection of Metal Ions with AgNPs
The stock solutions of different metal ions were prepared by dissolving a known amount of nitrate or chloride i.e. 0.5 mM in 10 ml. After that 1 ml of each solution of different metal ions were added into the prepared yellow AgNPs solution (3 ml). It was observed that all metal ions giving their own color, but in case of Hg2+ ions solution the yellow color of the AgNPs changes into colorless (Fig. 3).
Due to these facts further observations were taken by different concentrations of Hg2+ ions. From that it was observed that as the concentrations of these ions increases, there is more change in color as well as in UV spectra (Fig. 3 and 4).
Figure 3: Color change observed after the addition of 1 ml of Hg2+ ion solution in 3 ml AgNPs.
 Click on image to enlarge |
Figure 4: Effect of different concentrations of Hg2+ ions on AgNPs.
 Click on image to enlarge |
Figure 5: UV-Vis absorption response of 3 ml AgNPs solution on addition of Hg2+ ions (100-1000 µl).
 Click on image to enlarge |
As the concentrations of Hg2+ ions increases, there is accompanying with the broadening and blue shifting of the SPR band (Fig. 5). The results demonstrate that by adding a known concentration of Na+, Mg2+, Ca2+, Fe2+, Ni2+, Mn2+, Cu2+, Zn2+, Co2+, Cd2+ have no obvious effect on the absorption band and giving their own color to yellow colored AgNPs solution but by adding same concentration of Hg2+ ion, which changes color of solution from yellow to colorless and no band observed in UV spectra which indicates that the colorimetric approach has very high selectivity and specificity toward Hg2+ ion as compared to other transition metal ions, alkali and alkaline earth metal ions. It was observed that synthesized AgNPs are not significantly sensitive to other transition metal, alkali metal and alkaline metal ions under similar conditions.
Antibacterial studies of AgNPs using fructose with E. Coli
The antibacterial activity of AgNPs with E. Coli was measured by cup diffusion method. The media of nutrient agar was prepared. Nutrient agar (8.4 g) was dissolved in 300 ml distilled water. Its pH was maintained at 6. Then it was autoclaved at 15 lbs pressure and 121oC for 45 min. The sterilized medium was poured into different sterilized petri plates in laminar and was allowed to solidify. E. Coli (50 µL) was allow to fix with spreader in each plate and different concentration of AgNPs were poured in the holes i.e. (20, 40, 60, 80,100 ppm of AgNPs). After that these plates were incubated for 24 hr. After 24 hours it was observed that growth of bacteria was inhibited. The growth inhibition ring of E. Coli treated by AgNPs using fructose was 4 mm, 9 mm and 13 mm at 20 ppm, 40 ppm and 80 ppm respectively (Fig. 6).
Figure 6: Antibacterial activity at different concentration of AgNPs with E.Coli.
Click on image to enlarge |
Conclusions
In present work, fructose capped AgNPs was synthesized and characterized by UV-Vis, IR, SEM and XRD techniques. The yellow colors of solution of AgNPs were observed which were further used for the colorimetric detection of different metal ions. It was found on the presence of Hg²⁺ ion, the yellow colored AgNPs solution changing to colorless, accompanying the broadening and blue shifting of SPR band. The effect of color change prepared AgNPs toward other transition metal ions, alkali metal ions and alkaline earth metal ions were also studied. The effect of the concentration of Hg²⁺ to the AgNPs was also considered, from which it has been concluded that with increase in concentration of Hg²⁺ ion, there is broadening in band and shifting to the lower wavelength taking place. So it can be used as sensing material for the detection of Hg2+ ions in colorimetric studies. The application of AgNPs as an antimicrobial agent was investigated by growing E. Coli on nutrient agar plates. When nanoparticles were present on nutrient agar plates, they could effectively inhibit bacterial growth by adding AgNPs solution, which confirms that these particles have an excellent bacterial effect and effectiveness in reducing bacterial growth for practical applications.
Conflict of Interest
The authors confirm that this article content has no conflicts of interest.
Acknowledgements and Funding Source
Authors are thankful to Govind Ballabh Pant University of Agriculture & Technology for providing financial support for all experimental studies.
References
- J. Wang, X Feng, C. W. Anderson, Y. Xing, L. Shang. Remediation of mercury contaminated sites-A review. J. Hazard. Mat. 2012;221:1-18.
CrossRef - E. M. Nolan, S. J. Lippard, Tools and tactics for the optical detection of mercuric ion. Chem. Rev. 108, 3443-3480 (2008).
CrossRef - H. Prestel, A. Gahr, R. Niessner. Detection of heavy metals in water by fluorescence spectroscopy: on the way to a suitable sensor system. Fres. J. Anal. Chem. 2000;368:182-191.
CrossRef - A. K. Singh, R. P. Singh, S. Mehtab. Mercury-selective membrane electrode based on methyl substituted dibenzotetraphenyltetraazamacrocycle. J. Incl. Phen. Macrocyclic Chem. 2008;60:9-15.
CrossRef - Y. Wang, F. Yang, X. Yang. Colorimetric detection mercury(II) ion using unmodified silver nanoparticles and mercury-specific oligonucleotides. ACS Appl. Mater. Interfaces. 2010;2:339-342.
CrossRef - V. Kumar, N. Mehta, S. K. Kailasa, Hui-Fen. Wu. Sensitive and selective colorimetric sensing of Fe3+ ion by using p-amino salicylic acid dithiocarbamate functionalized gold nanoparticles. New J. Chem. 2014;38:1503-1511.
CrossRef - M. R. Knecht, M. Sethi. Bio-inspired colorimetric detection of Hg2+ and Pb2+ heavy metal ions using Au nanoparticles. Anal. Bioanal. Chem. 2009;394:33-46.
CrossRef - P. C. Lee, D. J. Meisel. Adsorption and surface-enhanced raman of dyes on silver and gold sols. Phys. Chem. 1982;86:3391-3395.
CrossRef - P. V. Kamat, M. Flumiani, G. V. Hartland. Synthesis and characterization of Au/TiO2 core-shell structure nanoparticles. J. Phys. Chem. B. 1998;102:3123-3128.
CrossRef - A. S. Nair, T. Y. Pradeep. Halocarbon mineralization and catalytic destruction by metal nanoparticles. Current Science. 2003;84:1560-1568.
- Y. J. Fang. In situ SU-8 silver nanocomposites. Chem. Phys. 1998;108:4315-4320.
- A.Sileikaite, I. Prsycevas, J. Puiso, A. Juraitis. Invention disk of nano-particles of silver discs and fast adsorption material to treatment water in dam. J. Mat. Sci. 2006;12:287-291.
- Z. Wang, L. Ma. Impedimetric aptasensor for ochratoxin A determination based on Au nanoparticles stabilized with hyper-branched polymer. Coord. Chem. Rev. 2009;253:1607-1618.
CrossRef - K. Saha, S. S. Agasti, C. Kim, X. Li, V. M. Rotello. Gold nanoparticle-biological molecule interactions and catalysis. Chem. Rev. 2012;112:2739-2779.
CrossRef - P. Lundahl, R. Stokes, E. Smith, R. Martin, D. Graham. Colloidal synthesis of silver nanoparticles. Micro Nano Letters. 2008;3:62-65.
- S. D. Solomon, M. Bahadory, A. V. Jeyarajasingam, S. A. Rutkowsky, C. Boritz, L. Mulfinger. Synthesis and study of silver nanoparticles. J. Chem. Edu. 2007;84:322-325.
CrossRef - Y. Yadong, Li Zhi-Yuan, Z. Ziyi, B. Gates; S. Venkateswaran. Synthesis and characterization of stable aqueous dispersions of silver nanoparticles through the Tollens process. J. Mate. Chem. 2002;12:522-527.
- Y. He, Y. Wu, G. Lu, Shi. A facile route to silver nanosheets. Mat. Chem. Phys. 2006;98:178-182.
CrossRef - Y. Sato, J. J. Wang, D. N. Batchelder, D. A. Smith. Controlled green synthesis of silver nanoparticles by Allium cepa and Musa acuminata with strong antimicrobial activity. Langmuir. 2003;19:6857-6862.
- D. Vilela, M. C. González, A. Escarpa. Sensing colorimetric approaches based on gold and silver nanoparticles aggregation: chemical creativity behind the assay. A review.Anal. Chim. Acta. 2012;751:24-43.
CrossRef - M. Annadhasan, T. Muthukumarasamyvel, V. R. Sankar Babu,N. Rajendiran. Green Synthesized Silver and Gold Nanoparticles for Colorimetric Detection of Hg2+, Pb2+, and Mn2+ in Aqueous Medium. ACS Sustainable Chem. Eng. 2014;2:887-896.
CrossRef - C. Sonnichsen, B. M. Reinhard, J. Liphardt, A. P. Alivisatos. A molecular ruler based on plasmon coupling of single gold and silver nanoparticles. Nat. Biotechnol. 2005;23:741-745.
CrossRef - M. Forough, K. Farhadi. Green synthesis and characterization of silver nanoparticles. Turk. J. Eng. Environ. Sci. 2010;34:281-287.
- R.O. Becker. Synthesis of silver nanoparticles from different plant leaf extracts and its analysis using UV spectroscopy. Met. Based Drugs. 1999;6:297-300.
- Ratyakashi, R. P. Chauhan. Synthesis and characterization of silver nanoparticles. Asian J. Chem. 2009;21: 113-116.
- K. Jadhav, S. L. Deore, D. Dhamecha, R. H. Rajeshwari, S. Jagwani, S. S. Jalalpure, R. A. Bohara. Phytosynthesis of silver nanoparticles: characterization, biocompatibility studies and anticancer activity. ACS Biomaterials Science & Engineering. 2018;4(3):892–899.
CrossRef - R. A. Bohara, N. D.Thorat, S. H. Pawar. Role of functionalization: strategies to explore potential nano-bio applications of magnetic nanoparticles. RSC Advances. 2016;6(50), 43989–44012.
CrossRef - C. Pettegrew, Z. Dong, M. Z. Muhi, S. Pease, M.A. Mottaleb, and M.R. Islam, Silver nanoparticle synthesis using monosaccharides and their growth inhibitory activity against gram-negative and positive bacteria. ISRN Nanotech. 2014;480284:1-8.
CrossRef - P. V. Kamat, M. Flumiani, G. V. Hartland. Silver ion reduction with peat fulvic acids. J. Phys. Chem.B. 1998;102:3123-3128.
CrossRef - G. J. Z Hao, S. E. Stevens. Multiple parameters for the comprehensive evaluation of the susceptibility of Escherichia coli to the silver ion. Biometals. 1998;11:27-32.
CrossRef - S. Amrut, J. S. Sharma, B. P. Ramchandra. Synthesis of silver nanoparticles: a safer alternative to conventional antimicrobial and antibacterial agents. J. Chem. Pharm. Res. 2010;2:478-483.
- R. M. Slawson, M. I. Van Dyke, H. Lee, J. T. Trevors. Germanium and silver resistance, accumulation, and toxicity in microorganisms. Plasmid. 1992;27:72–79.
CrossRef - I. Sondi, B. Salopek-Sondi. Silver nanoparticles as antimicrobial agent: a case study on E. Coli as a model for Gram-negative bacteria. J. Coll. Interface Sci. 2004;275:177-182.
CrossRef - K. H. Cho, J. E. Park, T. Osaka, S. G. Park. Silver nanoparticles in cosmetics. Electrochimica Acta. 2005;51:956-960.
CrossRef - P. Sanpui, A. Murugadoss, P. V. D. Prasad, S. S. Ghosh, A. Chattopadhyay. Green synthesis of silver and copper nanoparticles using ascorbic acid and chitosan for antimicrobial applications. Internat. J. Food Microbiology. 2008;124:142-146.
CrossRef - E. J. D. David, C. George. Synthesis and optical properties of silvernanoparticles and arrays. Chem. Phys. Chem. 2005;6:1221-1231.
CrossRef - P. Vasileva, T. Alexandrova, I. Karadjova. Application of Starch-Stabilized Silver Nanoparticles as a rimetric Sensor for Mery(II) in 0.005 mol/L Nitric Acid. J. Chem. 2017;6897960:1-9.
CrossRef












